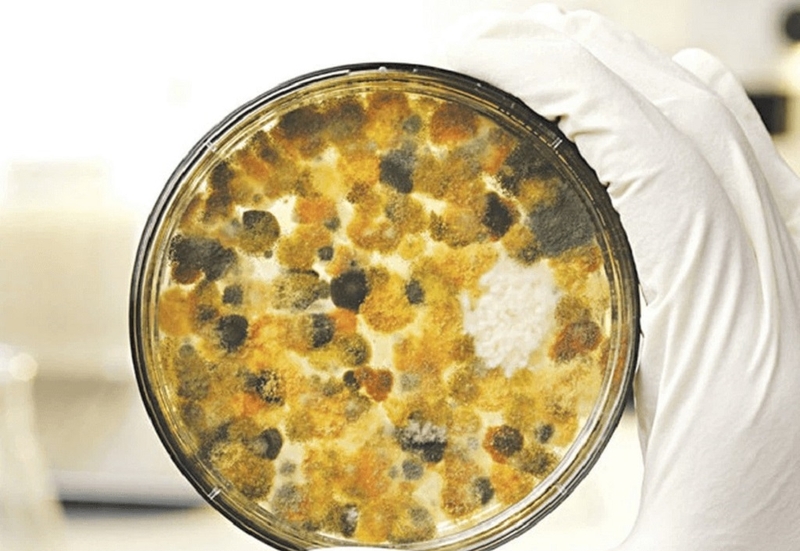
Aflatoxin là gì? Nguyên nhân nấm Aflatoxin có trong thực phẩm mốc dễ gây bệnh ung thư 1

Dược sĩ chuyên ngành Dược lâm sàng, với nhiều năm kinh nghiệm làm việc trong lĩnh vực dược phẩm. Là Dược sĩ Long Châu đạt được chứng chỉ bệnh học cấp quốc tế. Hiện đang là giảng viên tại Trung tâm Đào tạo FPT Long Châu.
Ánh Vũ
25/03/2024
Mặc định
Lớn hơn
Ngoài tác động gây ra ung thư gan, Aflatoxin cũng được biết đến là nguyên nhân gây ra nhiều loại ung thư khác nhau như ung thư dạ dày, ung thư thận, ung thư trực tràng, ung thư vú, buồng trứng, và ruột non. Nó cũng có khả năng gây ra các tác động như dị dạng cơ thể, đột biến gen và gây ra tình trạng quái thai.
Aflatoxin, thường xuất hiện trong thực phẩm bị nấm mốc, là một loại độc tố từ vi khuẩn nấm tự nhiên, được sản xuất bởi một số loài Aspergillus, một loại nấm mốc. Ngoài việc gây ra tình trạng ngộ độc cấp tính (với liều khoảng 10mg có thể gây tử vong), Aflatoxin cũng được coi là một trong những nguyên nhân gây xơ gan và ung thư gan.
Có thể bạn đã từng nghe đến Aflatoxin nhưng vẫn chưa biết Aflatoxin là gì? Aflatoxin là một loại độc tố tự nhiên được sản xuất bởi một số loài aspergillus, thường phát triển trên các hạt ngũ cốc, hạt có dầu và các sản phẩm củ. Aspergillus khi nhìn bằng mắt thường sẽ có màu xanh lá cây, nhưng khi sản sinh Aflatoxin thì chúng không có mùi, vị hoặc màu sắc và có thể chịu được nhiệt độ lên đến 280 độ C. Do đó, các phương pháp nấu và chế biến thông thường không thể hoàn toàn tiêu diệt độc tính của nó, khiến cho việc loại bỏ Aflatoxin một khi nó đã xuất hiện trở nên rất khó khăn.
Aflatoxin là gì? Aflatoxin được chia thành 6 hợp chất, trong đó hợp chất Aflatoxin B1 có độc tính mạnh nhất. Theo tài liệu nghiên cứu của Cục Dược phẩm và Thực phẩm (FDA) Hoa Kỳ, Aflatoxin rất bền với nhiệt. Mặc dù việc rang các loại hạt với nhiệt độ cao có thể tiêu diệt các bào tử nấm mốc nhưng độc tố của chúng vẫn không bị phá hủy hoàn toàn. Do đó, khi phát hiện hạt bị mốc, việc nên bỏ đi là cần thiết, bởi dù có chế biến ở nhiệt độ cao thì việc tiêu diệt hoàn toàn độc tố vẫn là không khả thi.
Độc tố Aflatoxin được biết đến là một trong những nguyên nhân chính gây ra ung thư gan mạnh mẽ nhất. Khi cơ thể tiếp xúc với Aflatoxin qua đường miệng và tiêu thụ một tổng lượng 2,5mg trong khoảng thời gian 90 ngày, nó có thể dẫn đến bệnh ung thư gan trong hơn 1 năm sau đó.
Dùng thực phẩm chứa nấm mốc Aflatoxin có thể gây ra nguy cơ ung thư, tuy nhiên nhiều người vẫn chưa thực sự hiểu vấn đề này. Một số có quan điểm đơn giản là chỉ cần loại bỏ nấm mốc bằng cách chà rửa và phơi khô thì đã loại bỏ hết độc tính và có thể sử dụng thực phẩm.
Thực ra, Aflatoxin không chỉ độc hại vì nó tồn tại trong thực phẩm bị mốc mà còn bởi tính dai dẳng của nó. Nguyên nhân gây bệnh ung thư của Aflatoxin là gì? Aflatoxin được sản sinh dưới dạng hóa học, do đó nó không bị phá hủy bởi nhiệt độ cao như nhiệt độ sôi 100 độ C. Nghiên cứu đã chỉ ra rằng, để loại bỏ một phần của Aflatoxin, cần phải sử dụng nhiệt độ cao hơn nhiệt độ sôi, thường là từ 1500 đến hơn 2000 độ C.
Khi Aflatoxin xâm nhập vào cơ thể, gan sẽ chuyển hóa nó thành các dạng trung gian hoạt động hoặc biến nó thành Aflatoxin M1, ít độc hại hơn. Có ít nhất 13 dạng khác nhau của Aflatoxin tự nhiên, trong đó Aflatoxin B1 là loại độc nhất. Các loại khác như Aflatoxin G1, G2 được sản sinh từ Aspergillus parasiticus, trong khi Aflatoxin B1 được sản sinh bởi Aspergillus flavus và Aspergillus parasiticus. Aflatoxin M1, M2 được tìm thấy trong sữa bò khi chúng ăn thức ăn chứa nấm mốc Aflatoxin.
Mọi loại động vật đều có thể nhiễm Aflatoxin. Người trưởng thành thường có khả năng miễn dịch tốt hơn nhưng trẻ em khi tiêu thụ thực phẩm chứa nấm mốc Aflatoxin có thể gặp vấn đề về tăng trưởng và phát triển.
Aflatoxin là gì? Aflatoxin khi tiếp xúc với cơ thể sẽ tác động chủ yếu vào gan, gây ra các vấn đề về gan và ung thư. Người tiếp xúc lâu dài với Aflatoxin có nguy cơ cao mắc ung thư gan và ung thư túi mật.

Ở phần trên chúng ta đã biết Aflatoxin là gì? Theo quy định của Cơ quan Quản lý Thực phẩm và Dược phẩm Hoa Kỳ (FDA), hàm lượng nấm mốc Aflatoxin trong thức ăn chăn nuôi và thực phẩm được chỉ định như sau:
Theo quy định của Bộ Y tế Việt Nam, hàm lượng Aflatoxin được giới hạn tối đa (ML) như sau:
Những mức giới hạn này được thiết lập để đảm bảo an toàn cho sức khỏe của người tiêu dùng và động vật, bằng cách giảm thiểu rủi ro từ việc tiếp xúc với Aflatoxin qua thực phẩm.

Với sự tiến bộ trong lĩnh vực y học, hiện nay có hai phương pháp chính để xác định mức độ nhiễm độc tố Aflatoxin ở người:
Tuy nhiên, cần lưu ý rằng việc sử dụng các phương pháp này cần được thực hiện bởi các chuyên gia y tế có kinh nghiệm và kết quả của các xét nghiệm này chỉ mang tính chất tham khảo và không phản ánh toàn bộ tình trạng sức khỏe của người nghi ngờ bị nhiễm Aflatoxin.
Đến nay, không có loại thuốc nào được chứng minh có khả năng điều trị đặc hiệu cho nhiễm độc tố Aflatoxin. Tuy nhiên, việc tìm hiểu kỹ Aflatoxin là gì để tránh xa các thực phẩm chứa nấm mốc Aflatoxin và duy trì một chế độ ăn uống giàu rau xanh, giàu chất chống oxy hóa có thể giúp giảm nguy cơ mắc bệnh ung thư, đặc biệt là ung thư gan.

Như vậy, Nhà thuốc Long Châu vừa chia sẻ kiến thức chi tiết về Aflatoxin là gì giúp bạn đọc hiểu rõ hơn về loại nấm này. Aflatoxin là một loại độc tố gây nguy hiểm cho sức khỏe người sử dụng. Thông qua việc cung cấp thông tin trên, chúng tôi hy vọng sẽ nâng cao nhận thức của cộng đồng về an toàn thực phẩm, giúp mọi người tự tin hơn trong việc chọn lựa và sử dụng thực phẩm hàng ngày.
Dược sĩ Đại họcPhạm Nguyễn Hoàng Kim
Dược sĩ chuyên ngành Dược lâm sàng, với nhiều năm kinh nghiệm làm việc trong lĩnh vực dược phẩm. Là Dược sĩ Long Châu đạt được chứng chỉ bệnh học cấp quốc tế. Hiện đang là giảng viên tại Trung tâm Đào tạo FPT Long Châu.